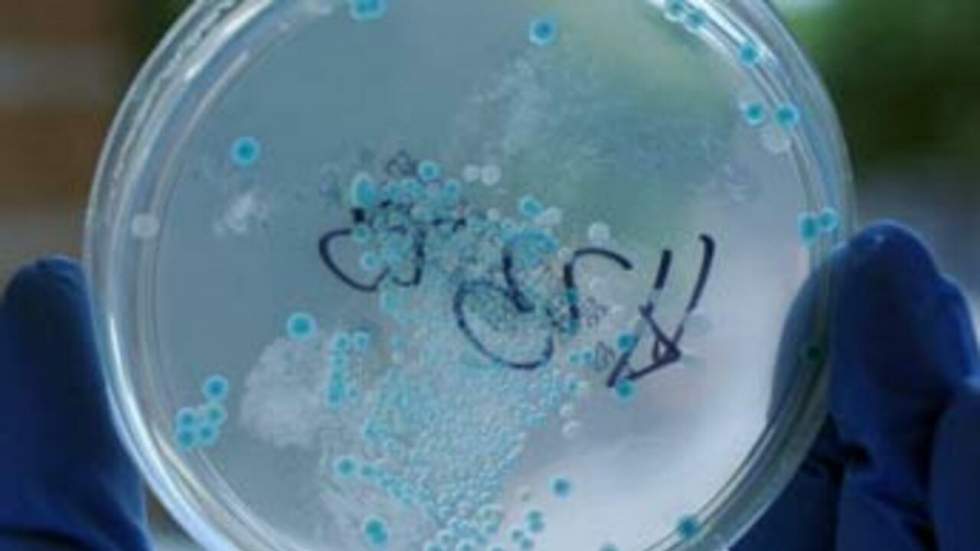

Les ministres de l'Agriculture des pays membres de l'Union européenne (UE) ont convenu d'aider à hauteur de 150 millions d'euros les maraîchers dont les ventes ont enregistré une importante chute depuis la crise liée à la bactérie E.coli.
AFP - Le commissaire européen à l'Agriculture, Dacian Ciolos, a proposé mardi une aide de plus de 150 millions d'euros pour soutenir les producteurs de légumes européens dont les ventes se sont effondrées à la suite de la crise de confiance causée par l'épidémie de la bactérie Eceh.

"On va proposer un montant de 150 millions d'euros" d'aides financières pour couvrir les pertes des agriculteurs, a déclaré Dacian Ciolos à son arrivée à une réunion extraordinaire des ministres européens de l'Agriculture à Luxembourg.
Il a toutefois précisé que c'était une estimation de départ, susceptible d'augmenter en fonction des estimations de pertes par les différents pays concernés.
"Il faut que la solidarité européenne soit à la hauteur", a exigé mardi à son arrivée la ministre belge de l'Agriculture, Sabine Laruelle, qui estime que les pertes du secteur pourraient aller jusqu'à "des centaines de millions d'euros".
Cette aide viendrait s'ajouter à des mesures de flexibilité en faveur des organisations de producteurs (35% de la profession en Europe), aujourd'hui seules autorisées à rembourser les invendus. L'UE pourrait décider une hausse des plafonds d'indemnisation des invendus, actuellement limités à 5% de la valeur annuelle de production.
Les quelque 150 millions d'euros proposés mardi seraient ouverts au contraire à tous les producteurs. Ils seraient indemnisés à hauteur de 30% du prix de référence de juin de ces dernières années des légumes les plus touchés - concombres, tomates et salades -, a précisé M. Ciolos.
Le fait que les fonds supplémentaires sont tirés du budget européen devrait satisfaire les pays qui, comme la France, refusent de débourser un centime pour indemniser cette crise partie d'Allemagne.

Mais ils ont été jugés insuffisants par l'Espagne, premier exportateur de fruits et légumes en Europe, qui a vu ses ventes s'effondrer depuis que ses concombres ont été mis en cause --à tort-- par les autorités allemandes.
La ministre espagnole, Rosa Aguilar a insisté pour que les agriculteurs soient remboursés à 100%, à l'instar de son homologue français Bruno Le Maire, qui a réclamé "une indemnisation à l'euro près des pertes subies par les producteurs de légumes en France".
Madrid évalue ses pertes à environ 225 millions d'euros par semaine et veut que ce soit l'Allemagne qui endosse à 100% le dédommagement du préjudice, menaçant l'Allemagne de poursuites si elle si refuse.
Alors que la saison est à son apogée, la méfiance des consommateurs à l'égard des concombres, salades et tomates, coûte cher aussi aux producteurs allemands qui ont évalué leurs pertes à 50 millions d'euros.
Quant à la Fédération des produits frais, Freshfel Europe, elle a appelé mardi à ne pas oublier le reste du secteur, lui aussi durement touché par la crise.
Aujourd'hui, seuls les producteurs de fruits et légumes membres d'une organisation ont le droit de percevoir une indemnisation exceptionnelle pour leurs invendus, cofinancée par l'UE et les organisations.
Pour des raisons légales, l'aide d'urgence dégagée mardi devrait être versée aux organisations de producteurs, avec lesquelles les producteurs non affiliés seraient tenus de signer un contrat pour pouvoir en bénéficier. Elle permettrait d'indemniser les producteurs pour leurs produits invendus depuis le 26 mai, selon une source proche du dossier.
Les ministres évoqueront également les moyens d'améliorer la traçabilité et le système d'alerte sanitaire, alors que plusieurs pays, notamment la Russie, ont interdit l'importation de légumes européens en attendant que la source de la contamination par la bactérie Eceh soit identifiée.
